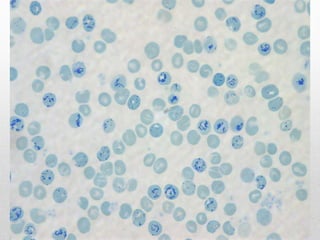
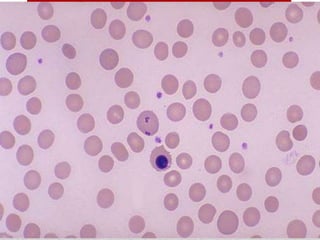
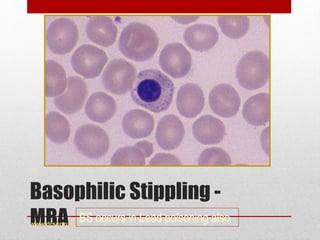
Basophilic Stippling -
MBAwww.drsarma.in
BS occurs in Lead poisoning also
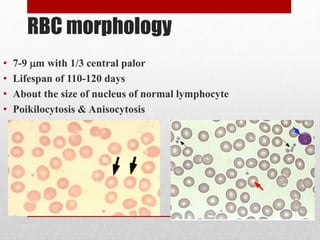
RBC morphology
• 7-9 m with 1/3 central palor
• Lifespan of 110-120 days
• About the size of nucleus of normal lymphocyte
• Poikilocytosis & Anisocytosis
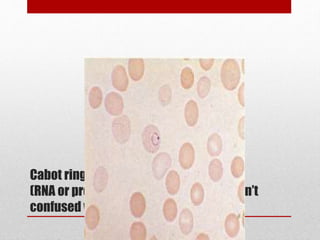
Cabot rings
(RNA or protein precipitation artifact don’t
confused with malaria)
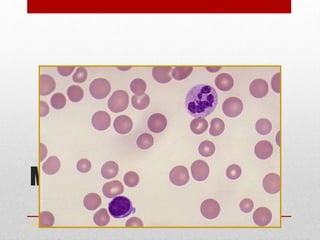
Macrocytosis -MBA
www.drsarma.in
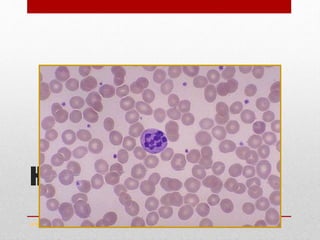
HSN - MBA
www.drsarma.in
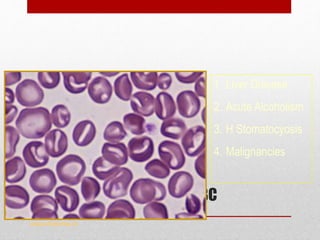
Stomatocytes
Slit like central pallor in RBC
www.drsarma.in
1. Liver Disease
2. Acute Alcoholism
3. H Stomatocyosis
4. Malignancies
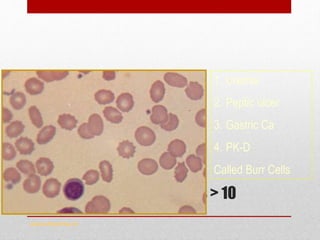
Echinocytes
Evenly distributed spicules > 10
www.drsarma.in
1. Uremia
2. Peptic ulcer
3. Gastric Ca
4. PK-D
Called Burr Cells
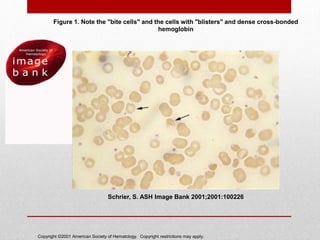
Copyright ©2001 American Society of Hematology. Copyright restrictions may apply.
Schrier, S. ASH Image Bank 2001;2001:100226
Figure 1. Note the "bite cells" and the cells with "blisters" and dense cross-bonded
hemoglobin
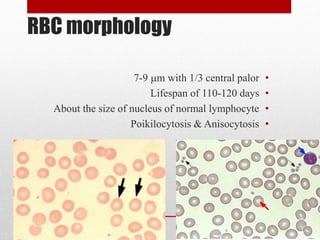
RBC morphology
•7-9 m with 1/3 central palor
•Lifespan of 110-120 days
•About the size of nucleus of normal lymphocyte
•Poikilocytosis & Anisocytosis

This document provides an overview of how to approach and evaluate anemia. It begins by defining anemia and describing a complete blood count. It then discusses evaluating the size, hemoglobin content, and distribution of red blood cells to classify anemia as microcytic, normocytic, or macrocytic. For each type of anemia, the document lists potential causes and recommends further tests. It also covers evaluating reticulocyte count, peripheral smear, and bone marrow biopsy findings to determine if anemia is caused by blood loss, increased destruction, or decreased production of red blood cells. The goal is to systematically narrow down the cause of anemia through a series of blood tests and examinations.